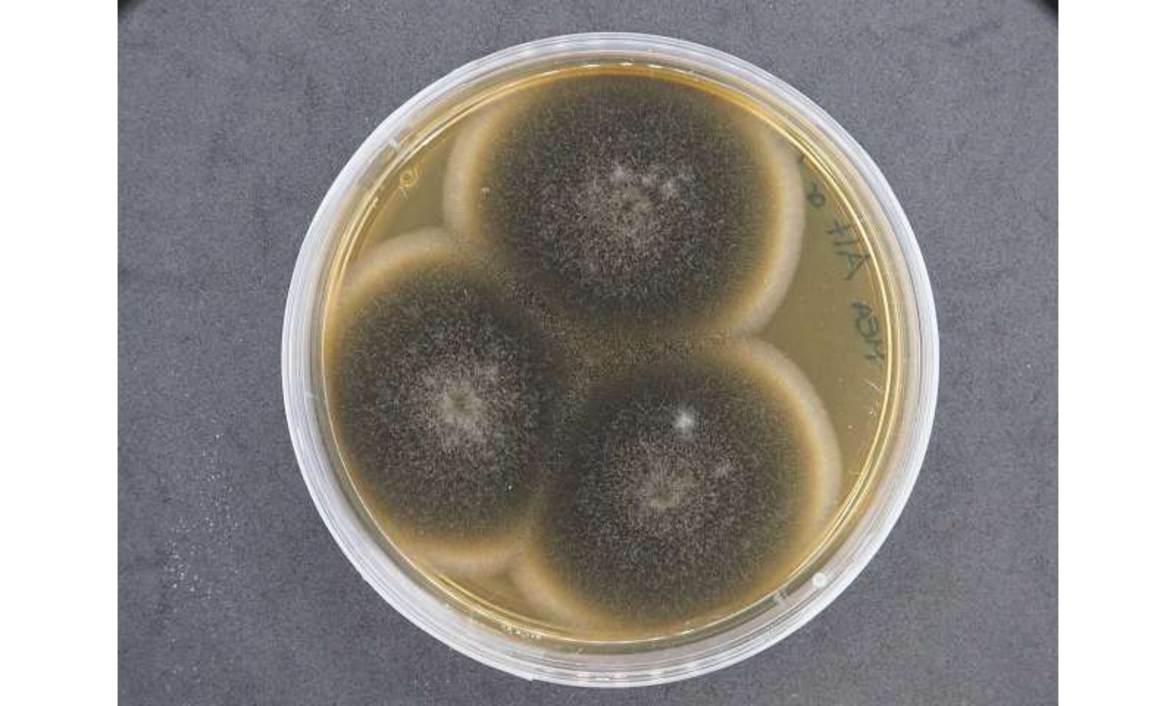

Пустыня Негев на юге Израиля славится своими уникальными наскальными рисунками.
По крайней мере с третьего тысячелетия до нашей эры охотники, пастухи и торговцы, обитавшие в Негеве, оставляли на скалах тысячи наскальных рисунков (петроглифов). Эти фигуры в основном вырезаны в "пустынном лаке" - тонком черном покрытии известняковой породы, которое образуется естественным путем. Многие из них изображают животных, таких как горные козлы, козы, лошади, ослы и домашние верблюды, но встречаются и абстрактные формы.
Исследование, опубликованное в журнале Frontiers in Fungal Biology, показало, что на петроглифах обитает сообщество редких специализированных грибков и лишайников. К сожалению, в долгосрочной перспективе эти виды могут представлять серьезную угрозу для наскальной живописи.
"Мы показали, что эти грибки и лишайники могут внести значительный вклад в постепенную эрозию и разрушение петроглифов", - рассказала Лаура Раббачин, аспирант Академии изящных искусств Вены (Австрия) и первый автор исследования. "Они способны выделять различные виды кислот, которые могут растворять известняк, в котором высечены петроглифы. Кроме того, грибки могут проникать и расти внутри каменных гранул, вызывая дополнительные механические повреждения".

Петроглиф с изображением человеческой фигуры. Фото: Laura Rabbachin, INTK, Академия изящных искусств, Вена
Раббачин и ее коллеги взяли образцы с места наскальных рисунков в центрально-западном нагорье Негева. Здесь выпадает в среднем всего 87 мм осадков в год, а температура на поверхности скал летом может подниматься до 56,3 °C. Исследователи брали образцы с пустынного лака рядом с петроглифами, со скал без пустынного лака и с почвы рядом с исследуемыми скалами. Они также оставили открытые чашки Петри рядом со скалами, чтобы собрать споры, переносимые по воздуху.
Авторы идентифицировали собранные грибки и лишайники с помощью двух взаимодополняющих методов. Во-первых, они неоднократно культивировали грибковый материал или споры со скал или почвы на чашках с одной из двумя различными ростовыми средами, пока не получали чистые изоляты для ПЦР-штрих-кодирования. Во-вторых, они непосредственно проводили секвенирование ДНК грибкового материала, присутствующего в образцах горных пород или почвы, без предварительного культивирования. Последний метод позволил обнаружить штаммы, которые не растут в культуре.
Оба метода показали, что разнообразие и обилие видов на скалах с петроглифами было низким по сравнению с почвой, что говорит о том, что немногие виды способны выдерживать местные экстремальные условия засухи и температуры.
Штрих-кодирование культивированных изолятов показало, что на петроглифах обитают многочисленные виды грибов из родов Alternaria, Cladosporium и Coniosporium, а прямое секвенирование выявило многочисленные виды из родов Vermiconidia, Knufia, Phaeotheca и Devriesia. Все виды, за исключением Alternaria и Cladosporium, являются так называемыми микроколониальными грибами, которые, как известно, процветают в жарких и холодных пустынях по всему миру. Также в изобилии встречались лишайники из рода Flavoplaca.
Культура грибков Alternaria sp. NS4. Фото: Laura Rabbachin, INTK, Академия изящных искусств, Вена
"Микроколониальные грибки считаются очень опасными для каменных артефактов. Например, они были названы вероятной причиной порчи каменного культурного наследия в Средиземноморье", - отметила Раббачин. "Хорошо известно, что лишайники также вызывают разрушение камней и, таким образом, представляют собой потенциальную угрозу для каменного культурного наследия".
В окружающей почве и воздухе исследователи обнаружили в основном различные космополитические грибы, которые, как известно, способны выживать в суровых условиях пустыни, производя засухоустойчивые споры. Можно ли что-то сделать, чтобы защитить петроглифы от медленной, но разрушительной работы наблюдаемых микроколониальных грибов и лишайников? Это маловероятно, предупреждают авторы.
"Эти естественные процессы выветривания невозможно остановить, но их скорость сильно зависит от того, изменится ли климат в будущем и как. Что мы можем сделать, так это следить за микробными сообществами с течением времени и, самое главное, подробно документировать эти ценные произведения искусства", - отметила Раббачин.
